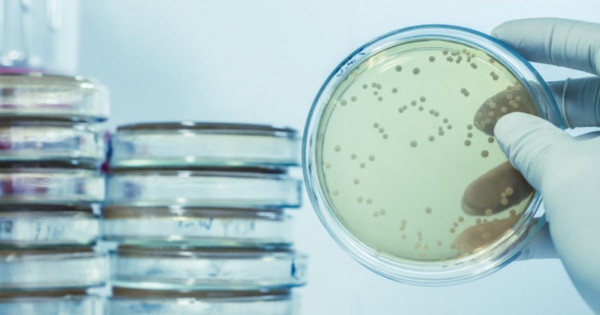

·
13/02/2026
Llamado a cobertura de cargo interino de la Cátedra de Microbiología
El Departamento de Ciencias Enológicas y Agroalimentarias de la Facultad de Ciencias Agrarias realiza un llamado para la cobertura de un cargo de Jefe de Trabajos Prácticos, dedicación semiexclusiva, carácter interino, en la Cátedra de Microbiología, del Departamento de Ciencias Enológicas y Agroalimentarias.

09/12/2025
Llamado a cobertura de cargo interino de la Cátedra de Administración Rural
El Departamento de Economía, Gestión, Desarrollo del Territorio y Ambiente realiza un llamado para la cobertura de un cargo de Ayudante de Segunda, dedicación simple, carácter interino, en la Cátedra de Administración Rural.
No hay más contenido disponible





